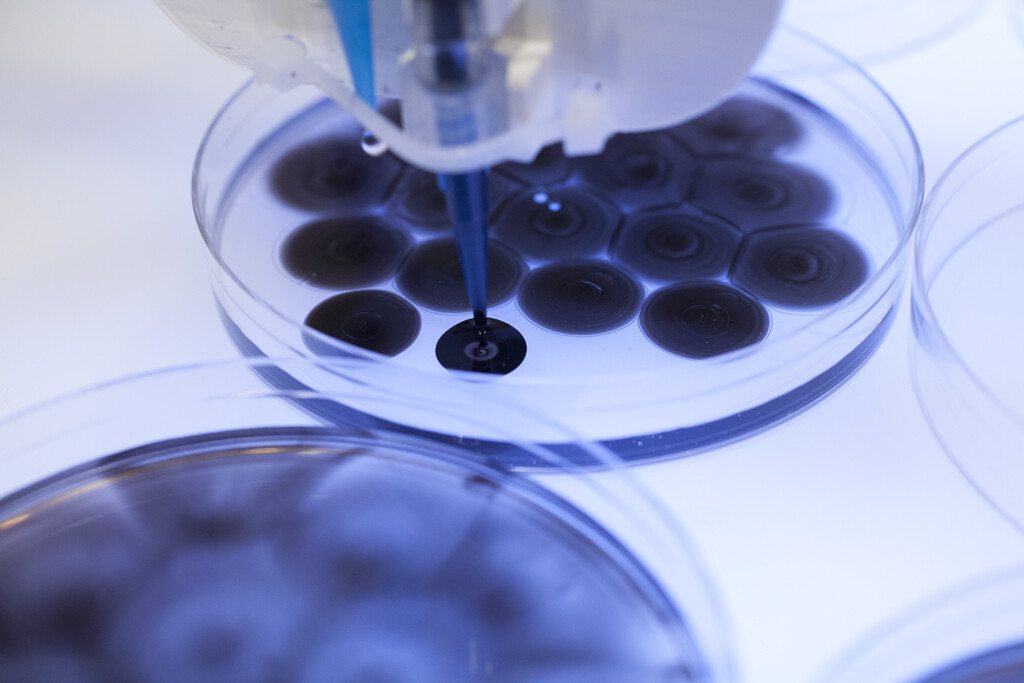

首届北京艺术与科技双年展(BATB)聚焦“合成生态” | 中国艺术报
科技赋能艺术,聚焦人与自然和谐共生——10月28日至2023年1月31日,由北京七九八文化科技有限公司与中央美术学院联合主办的首届北京艺术与科技双年展(BATB)“合成生态”(Synthetic Ecology)在北京798艺术区798CUBE举办。本次展览由中央美术学院设计学院院长宋协伟担任总策划,798CUBE执行馆长李东妊担任展览总监,陈小文与王乃一联合策展。
20世纪70年代,英国科学家詹姆斯·洛夫洛克首次提出“盖娅假说”,将地球看作一个超级有机体。这种全新的审视生命的方式,认为地球是“活”的,能够自我调节,维系生命体系的稳定性和持续性。“生态既是一个普遍关注的议题,更是一个被探索多年的议题。正是在这样的前提下,本届双年展借由‘合成’这一隐喻对‘共生本体’进行深刻回应,以多学科交织的视野探寻重塑自然的可能性,检视后人类的生态想象,进而形塑一种新的本体论层面的平等观。”王乃一介绍。

群体(2009年) 特瑞可·哈波亚 图片 © 特瑞可·哈波亚
作为798CUBE正式亮相的第一个展览,本届双年展邀请来自全球的50位艺术家、科学家、生态学家,以“合成生态”为主题进行创作的,作品被划分为“激变的自然”“缠绕的生命”“交织的演化”三个部分。三个篇章编织的多重生命网络,将思索的视界从“人/社会”推至“万物/宇宙”,在行星视角与行星尺度之中探讨未来演化的可能性。展览围绕气候变化、生态保护、环境可持续、未来构想等热门话题,探讨人与自然的共生关系,旨在用“艺术+科技”的震撼视觉呼吁关注、引发思考,从而促进大众绿色、可持续行动的落地,推动国家实现碳达峰、碳中和,助力建设人与自然和谐共生的中国式现代化进程。
生命机制(2011年) 奥隆·卡茨、爱奥纳特·祖尔 图片 © 组织培养和艺术项目(奥隆·卡茨、爱奥纳特·祖尔)
“合成生态”双年展将思考的视角从人延伸至万物、从社会拓展至宇宙,展览运用了生物技术、材料科学、数字制造、新兴媒体等多种前沿科技手段,启发大众对人与自然“如何共生”的思考,引发人类对未来共同命运的关注,从视觉和感官上给人带来了震撼的艺术体验。

网络的自然历史(2021年) 拉尔夫·贝克尔 图片 © 拉尔夫·贝克尔
本次展览中有25件艺术作品为首次在中国亮相,15件艺术作品是2021年至2022年期间的最新创作。其中,展厅内悬挂着的一件名为《降临》的作品引起公众的广泛关注,这件作品来自于中国著名艺术家向京。此外,重磅亮相于2021年英国格拉斯哥第26届联合国气候大会(COP26)的“气候时钟”项目也在双年展中呈现,“气候时钟”以倒计时作为一种凸显紧迫性的工具,来反思气候变暖这一全球议题,在对人类行为进行警示的同时,也传达了全世界在一条时间线上共呼吸的情感,激发人们共同行动,这也是该项目首次在中国亮相。

降临 向京
多种前沿科学复合交叉的艺术呈现,更是本届双年展的亮点之一,如:MIT媒体实验室教授内里·奥克斯曼借助生物技术、材料科学和数字制造技术设计“超自然”生态,在此之中,“生长”与“制造”交织互渗;英国艺术家亚历山德拉·黛西·金斯堡以数字化的形式复活已经消亡的物种,借此深刻反思新兴科技的力量赋予“存在”的意义;澳大利亚艺术家派翠西亚·匹斯尼尼的作品强调了不同生命形态之间的异质交错,这种对“混杂性”的致敬,揭示了我们与万物“共生起源”、忧患与共。

气候时钟

图腾 内里·奥克斯曼与介导物质组 (效果图由Luxigon工作室的艾瑞克·布罗什·库姆斯制作,图片由内里·奥克斯曼与介导物质组提供)
作为双年展的呈现之地,798CUBE是国内为数不多完全按国际美术馆专业标准设计和建造的艺术空间,由国际知名建筑师朱锫设计,融合传统与现代,兼具艺术中心功能和人文空间质感。798CUBE执行馆长李东妊表示,798CUBE希望带领大众探索更多无限可能,这有别于传统艺术中心的定位,将以艺术与科技为核心,通过跨界艺文内容和丰富多元的融合空间,吸纳全球创意人才聚集,建构跨地域、跨领域的文化创新共同体。在未来,798CUBE也会持续对各种国际文化艺术交流项目开放合作,关注各个国家年轻当代艺术家的交流,逐步建立开放的艺术生态环境,成为符合国际高水准的当代艺术空间、与全球顶尖艺术家合作的重要文化标志以及大众体验创新科技艺术的热门场所。

798CUBE中庭©金伟琦